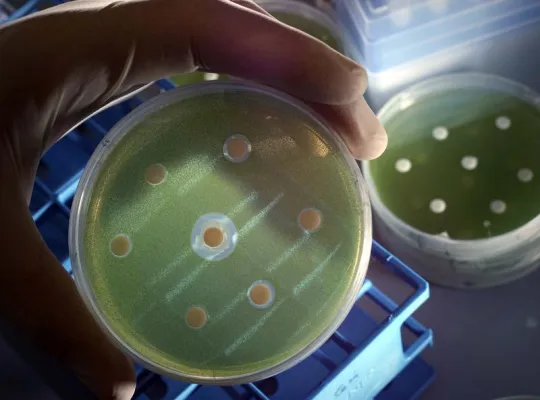
Treibjagd in der Petrischale Bild: Treibjagd in der Petrischale

(openPR) Sich einfach wohlfühlen - Überflüssige Pfunde purzeln durch "Fasten mit Mikroalgen" und gesund Abnehmen, indem die Sinne aktiviert werden "Viel mehr als nur gesunde Ballaststoffe sind langkettige Kohlenhydrate aus Braunalgen, so genannte Alginate, als Zusatz in Lebensmitteln. Sie können auch die Fettaufnahme stark verringern und damit helfen, Übergewicht zu bekämpfen", berichten britische Forscher. Das Unternehmen Energiestrategen GmbH (http://www.energiestrategen-gmbh.de/) beschäftigt sich in regelmäßigen Seminarveranstaltungen über die Entwicklung und Anwendungsgebieten der Mikroalgen. Welche Absatzmöglichkeiten stehen zur Verfügung und welchen Stellenwert kann Deutschland als Produktionsstandort zur Reinalgenzucht ausbauen?
Der Wunderkuchen der Azteken
Die spanischen Eroberer Mittelamerikas beobachteten, wie die Azteken feine Netze auf einem See auslegten und damit einen grünen Brei von der Wasseroberfläche abschöpften; dieser wurde in der Sonne getrocknet und hatte den Ruf von einer geheimnisvollen und stärkenden Wirkung. Leider geriet dieser Wunderkuchen in Vergessenheit, aber Jahrhunderte später erforschte der belgische Botaniker Jean Leonard einen merkwürdigen "blaugrünen Kuchen", den er auf den Eingeborenenmärkten im Tschad gefunden hatte. Dabei wurde der erstaunlich hohe Gehalt an hochwertigem Eiweiß festgestellt - es ist mehr darin enthalten als in allen anderen Nahrungsmitteln, jeweils bezogen auf das Trockengewicht. Heute ist bekannt, dass dieser Algenkuchen die ideale Nahrungsergänzung für alle Menschen darstellt - sowohl bei chronischer Mangelernährung als auch bei der heute weit verbreiteten "modernen" Fehlernährung.
Algen als Nahrungsergänzungsmittel - geringe Mengen entfalten zahllose heilende und harmonisierende Wirkungen
Spirulina Algen ist kein Mittel, das das Gewicht reduziert, aber es reguliert den Stoffwechsel und hat bei gleich bleibenden Ernährungsgewohnheiten eine deutliche Gewicht reduzierende Wirkung. "Wenn wir täglichen Nahrungsmitteln wie Brot oder Joghurt natürliche Ballaststoffe hinzufügen, könnten bis zu Dreiviertel des Nahrungsfettes den Körper einfach ungenutzt passieren", laut lain Brownlee aus der Arbeitsgruppe von Jeffrey Pearson von der Newcastle University. Die aus Braunalgen gewonnenen Alginate werden heute lediglich als Gelier- und Verdickungsmittel der Nahrung zugesetzt. Ähnlich wie Zellulose können sie im menschlichen Darm nicht abgebaut werden. Auf noch unbekannte Weise bewirken sie, dass etwa 75 Prozent weniger Nahrungsfett aus dem Darm in den Körper gelangt. Das ergaben biochemische Labortests mit einem künstlichen Darm, womit die Forscher mehr als 60 verschiedene Ballaststoffe daraufhin untersuchten, ob sie die Fettabsorption beeinflussen.
Forscher gehen der Frage nach: Was wenn sich der beobachtete Effekt auch bei Versuchspersonen erzielen ließe, wäre das wirksamer als jedes andere Mittel, das zurzeit für die Behandlung von Übergewicht frei verkäuflich erhältlich ist? Die Forscher haben schon zu prüfen begonnen, ob der Zusatz einer wirksamen Menge an Alginaten den Geschmack von Nahrungsmitteln verschlechtert. Erste Tests mit Brot seien sehr positiv verlaufen; täglich zugeführte funktionelle Nahrungsmittel könnten es übergewichtigen Menschen sehr erleichtern, ihr Körpergewicht zu verringern, ist sich die Forschung einig.
Der Algenmarkt
Jährlich werden ca. 4.000t Spirulina in Health-Food-Märkten verkauft, Tendenz steigend. Unter den europäischen Unternehmen wächst das Interesse an bioaktiven Substanzen aus Algen für den Einsatz in der Pharmaindustrie, Kosmetikbranche, Nahrungsmittelindustrie und als Futtermittelzusatz. Die Wachstumsrate von Mikroalgen liegen im Mittel weit über den terrestrischer Pflanzen. Mikroalgen stellen zusätzlich eine enorme natürliche Ressource zur Erzeugung von einer großen Zahl an Substanzen dar. Anbau und Produktion von Algen bieten Marktpotenzial und Deutschland eignet sich als Produktionsstandort, in Niedersachsen in Bassum und Essen entstehen Reinalgenzuchtanlagen in industrieller Modulbauweise. Mit Algen in die Zukunft, es bleibt spannend.
V.i.S.d.P.:
Wolfgang Seliger
Geschäftsführer / Managing Director
Der Verfasser ist für den Inhalt verantwortlich